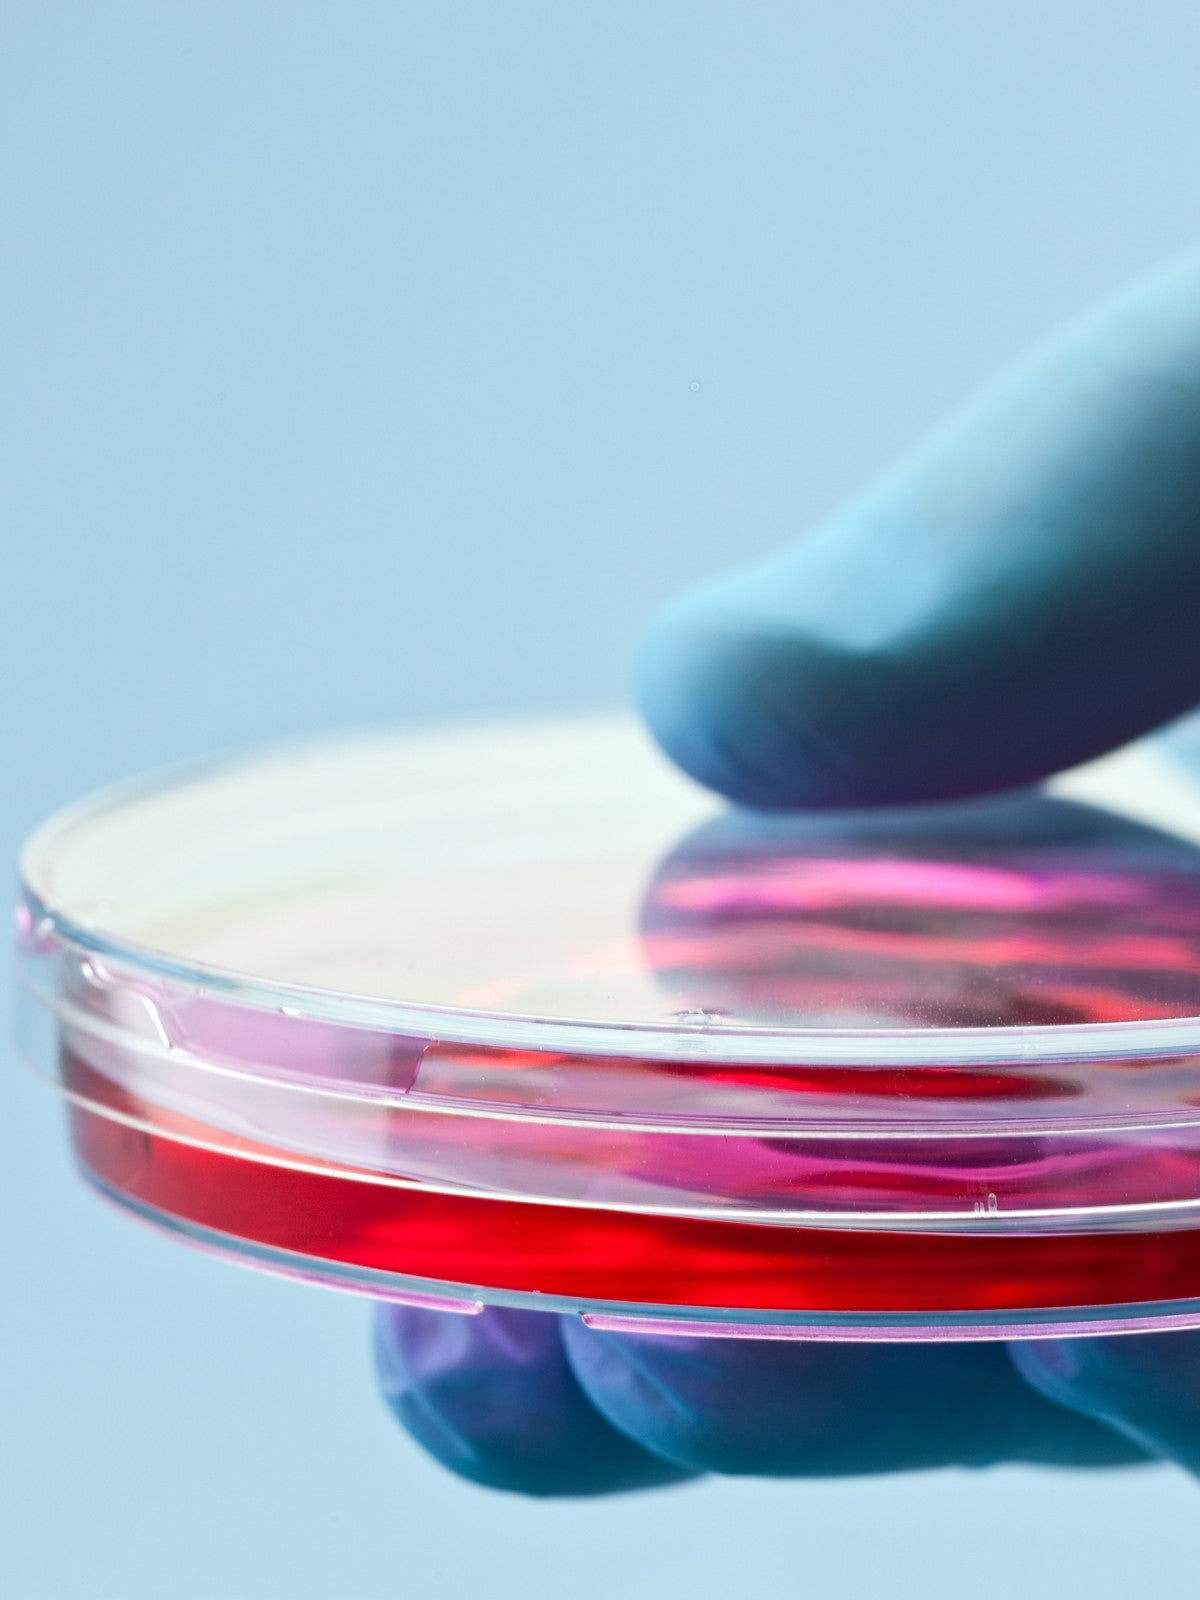

Human-Centric Regeneration
SkinSeqnc™ is a Canadian founded company providing a sequence of human-based and human-bioidentical cosmeceuticals formulated by the expertise of cellular regenerative professionals in cell biology research. SkinSeqnc™ was born out of a passion for transformative skincare that leverages the wonders of science and nature. Driven by innovation, authenticity, and the pursuit of excellence our vision is to bridge the gap between cutting-edge cellular research and effective skincare solutions.

At the heart of SkinSeqnc’s success is our team of accomplished cellular regenerative professionals and cell biology scientists. Their extensive knowledge and relentless pursuit of scientific breakthroughs allow us to push the boundaries of skincare innovation. With a deep understanding of cellular processes and how they relate to skin health, our experts have crafted a range of products that provide true rejuvenation from within.

At SkinSeqnc™, we believe that the key to unlocking your skin’s full potential lies within the harmony of human biology and advanced science. Our cosmeceuticals are meticulously designed to work synergistically with your body’s natural processes, tapping into the inherent power of human umbilical cord stem cells (hUC-MSCs) for exceptional results. The secretome from hUC-MSCs offers a cutting-edge blend of the most potent bioactive molecules, growth factors, cytokines, and extracellular vesicles, expertly curated to deliver unparalleled benefits to your complexion.

We take great care in crafting our products with precision, ensuring that they replicate the natural compounds found in your skin. Our human-bioidentical approach means that our cosmeceuticals contain ingredients identical to those naturally produced in your body. This nanotechnology method enhances compatibility, promoting better absorption and efficacy, while minimizing the risk of sensitivities or adverse reactions.
At the heart of SkinSeqnc’s success is our team of accomplished cellular regenerative professionals and cell biology scientists. Their extensive knowledge and relentless pursuit of scientific breakthroughs allow us to push the boundaries of skincare innovation. With a deep understanding of cellular processes and how they relate to skin health, our experts have crafted a range of products that provide true rejuvenation from within.
At SkinSeqnc™, we believe that the key to unlocking your skin’s full potential lies within the harmony of human biology and advanced science. Our cosmeceuticals are meticulously designed to work synergistically with your body’s natural processes, tapping into the inherent power of human umbilical cord stem cells (hUC-MSCs) for exceptional results. The secretome from hUC-MSCs offers a cutting-edge blend of the most potent bioactive molecules, growth factors, cytokines, and extracellular vesicles, expertly curated to deliver unparalleled benefits to your complexion.
We take great care in crafting our products with precision, ensuring that they replicate the natural compounds found in your skin. Our human-bioidentical approach means that our cosmeceuticals contain ingredients identical to those naturally produced in your body. This nanotechnology method enhances compatibility, promoting better absorption and efficacy, while minimizing the risk of sensitivities or adverse reactions.